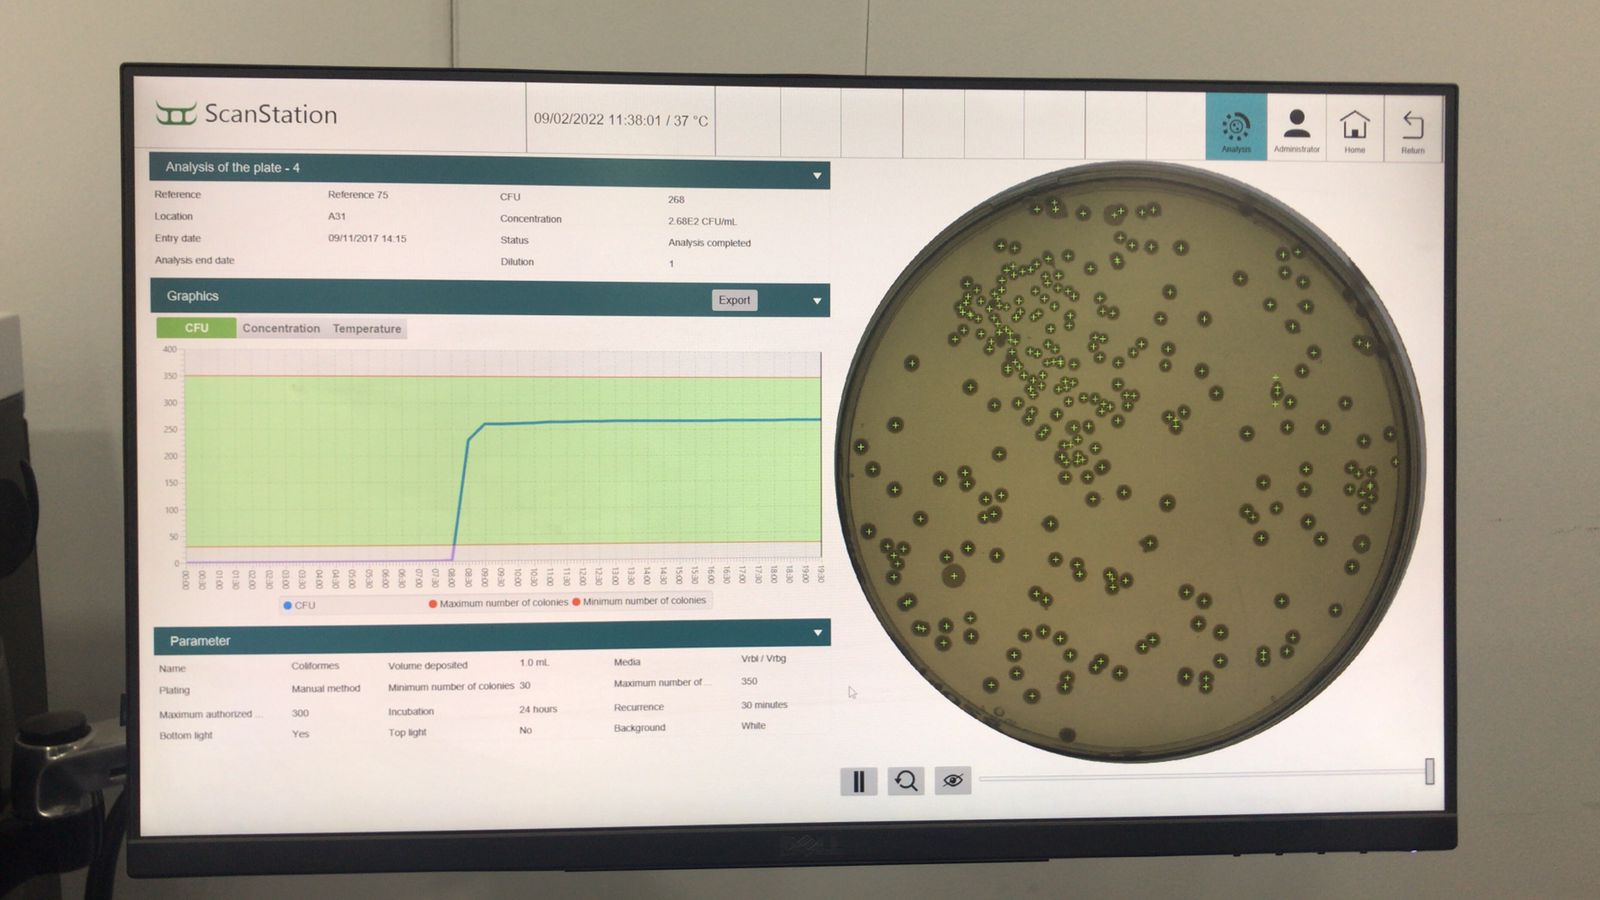

نظمت وحدة رعاية الموهوبين برنامج تدريبي لطالبات كلية الصيدلة وكلية للعلوم والدراسات الإنسانية تخصص الكيمياء والأحياء يوم الأربعاء ٩ فبراير.
حيث حصل الطالبات المتفوقات على تدريب بالمختبر المركزي بكلية العلوم والدراسات الإنسانية بالخرج على عدة تقنيات من ضمنها جهاز المطياف الضوئي ، قياس كثافة المعادن الثقيلة بماء الصنبور ، عزل وتنمية بكتيريا من استح مختلفة وتوثيق نموها بتقنية الزوال الزمني حيث كان عدد الطالبات ٦ طالبات متفوقات , اشرف على التدريب كلا من سعادة الدكتور مصطفى عيد والدكتور محمد عكيلة.